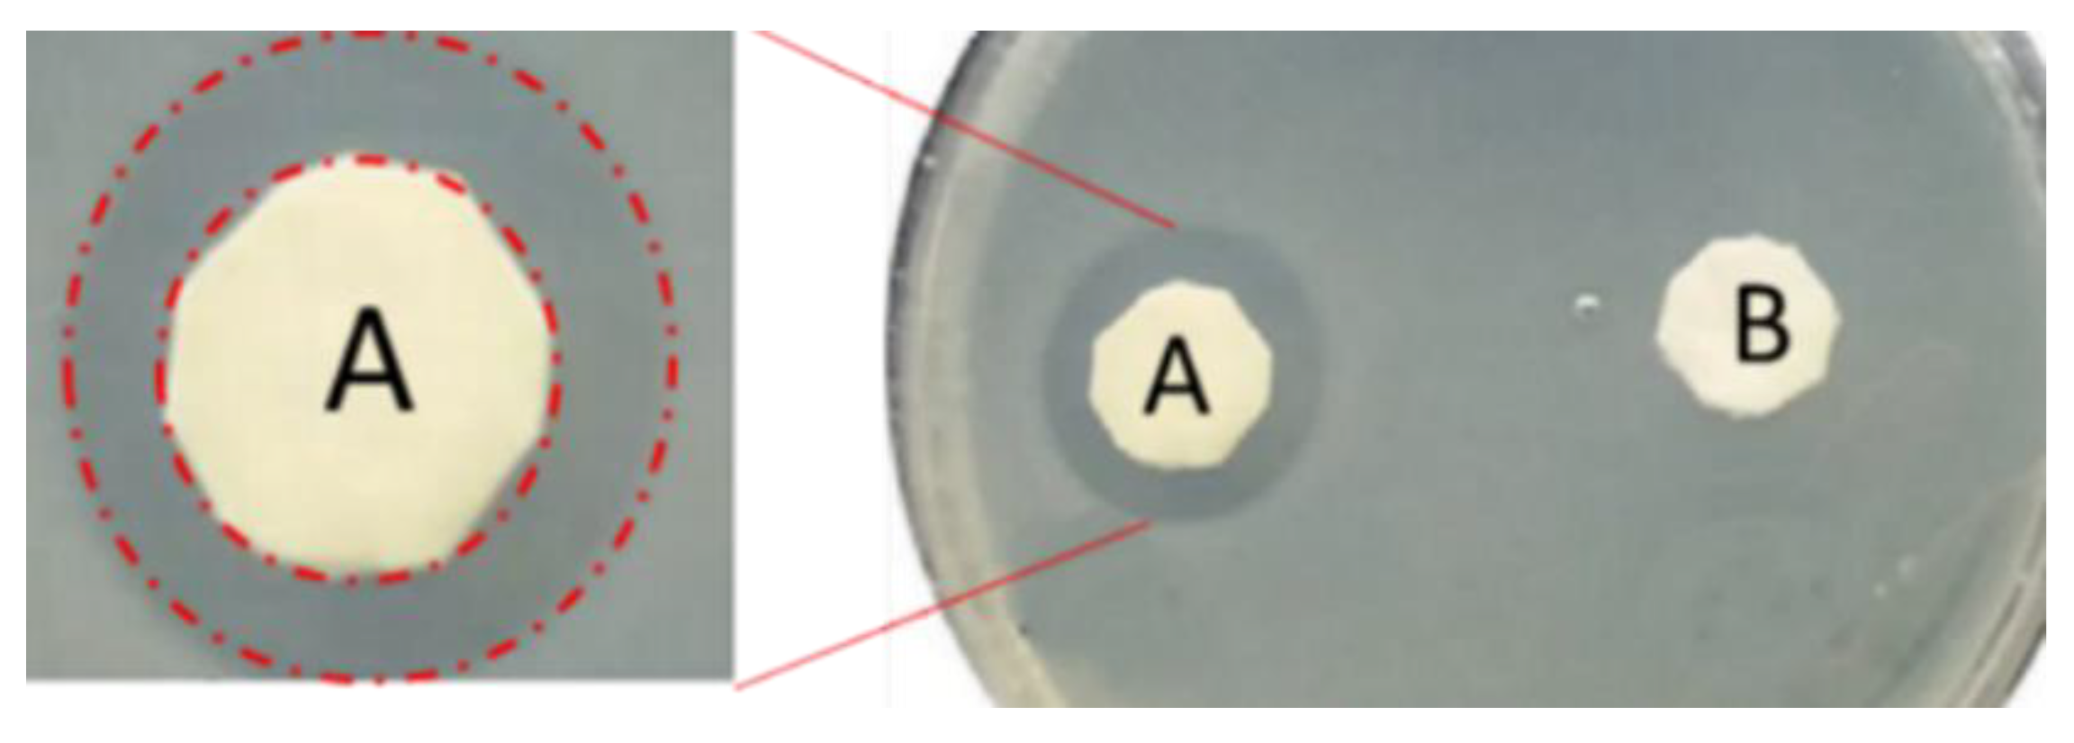

Sulfonated Pentablock Copolymer (NexarTM) for Water Remediation and Other Applications
Abstract
1. Introduction
2. Sulfonated Block-Copolymer for Water Purification
3. NexarTM Polymer for Water Remediation
3.1. NexarTM Properties
3.2. Desalination
3.3. Pervaporation
3.4. NexarTM Films for Adsorption Process
3.4.1. Heavy Metals Adsorption
3.4.2. Dyes Adsorption
3.5. NexarTM Photocatalytic Nanocomposites for Dyes Degradation
4. Nexar as Coating Layer of Commercial Filters
4.1. Antimicrobial and Antibiofouling Properties of Nexar
4.2. Nexar Coated PP Filters for Heavy Metals and Dyes Filtration
4.3. UV Treatment of Nexar Coated PP Filters
5. Other Applications of NexarTM
5.1. NexarTM in Energy Application
5.2. NexarTM for CO2 Capture and Dehumidification
6. Conclusions and Future Perspectives
- (a)
- Contaminant removal efficiencies, for practical applications, are strictly dependent on the polymeric structure. A good tradeoff between hydrophilicity and hydrophobicity is fundamental to obtaining good performance in filtration processes or ameliorating transport properties. For this scope, the structure of s-PBC, being formed by a hydrophobic backbone with hydrophilic functionalizations, plays a key role. Indeed, this molecular architecture is characterized by high hydrophilicity and high mechanical and thermal stability. Furthermore, its performance in terms of water uptake and transport is also affected by this architecture. Due to the presence of different polymeric units, it is formed by micellar structure affected by experimental parameters: its structure at nanolevel could be tailored by choice of the dispersing medium affecting its water uptake and transport properties. Taking advantage of these properties, NexarTM showed high performance in desalination, pervaporation, and filtration processes.
- (b)
- Another advantage of this polymer is represented by the presence of sulfonilic groups on polymeric chains. Indeed, with respect to unsulfonated polymers, the presence of sulfonic groups on the polymeric backbone confers polymer-specific properties, such as higher hydrophilicity and acidic character that favors antimicrobial and antifouling activities, and the presence of active sites useful for selective adsorption of contaminants. These properties make NexarTM a good candidate for water remediation applications.
- (c)
- Hybrid nanocomposite polymeric membranes could be easily prepared using the solvent casting method as free-standing films/membranes or as filter coating in adsorption, filtration, and photocatalytic processes for water purification. Embedded nanoparticles (graphene oxide, metal oxides) not only enhance the adsorption and filtration properties of Nexar itself, but they confer new functionalities such as photodegradation. Nexar acted both as a scaffold for photocatalytic NPs, avoiding their dispersion in the environment, and as an enhancer of the photocatalytic process. The main advantage of polymeric films is that they can be easily managed, regenerated, and reused without any release of nanomaterials into the environment. In particular, the Nexar properties and the reasons for its use were described, and several examples of its application for the removal of contaminants (i.e., microorganisms, organic molecules, and heavy metals) by different methodologies (such as adsorption, filtration, and photocatalysis processes) were reported.
- (d)
- The molecular architecture of NexarTM is also responsible for the excellent transport properties of these materials, making it a good candidate for other applications such as devices for gas transport (i.e., filters, CO2 capture, and dehumidification) or as a proton exchange membrane in electrochemical devices for energy conversion and in this case it showed better performance than the well-known Nafion.
Author Contributions
Funding
Acknowledgments
Conflicts of Interest
References
- Zou, C.; Ma, F.; Pan, S.; Lin, M.; Zhang, G.; Xiong, B.; Wang, Y.; Liang, Y.; Yang, Z. Earth energy evolution; human development and carbon neutral strategy. Petrol. Explor. Dev. 2022, 49, 468–488. [Google Scholar] [CrossRef]
- Gleeson, T.; Befus, K.; Jasechko, S.; Luijendijk, E.; Bayani Cardenas, M. The global volume and distribution of modern groundwater. Nat. Geosci. 2016, 9, 161–167. [Google Scholar] [CrossRef]
- Bashir, I.; Lone, F.A.; Bhat, R.A.; Mir, S.A.; Dar, Z.A.; Dar, S.A. Concerns and Threats of Contamination on Aquatic Ecosystems. In Bioremediation and Biotechnology; Hakeem, K., Bhat, R., Qadri, H., Eds.; Springer: Cham, Switzerland, 2022. [Google Scholar] [CrossRef]
- Zamora-Ledezma, C.; Negrete-Bolagay, D.; Figueroa, F.; Zamora-Ledezma, E.; Ni, M.; Alexis, F.; Guerrero, V.H. Heavy metal water pollution: A fresh look about hazards, novel and conventional remediation methods. Environ. Technol. Innov. 2021, 22, 101504. [Google Scholar] [CrossRef]
- Boretti, A.; Rosa, L. Reassessing the projections of the World Water Development Report. NPJ Clean Water 2019, 2, 15. [Google Scholar] [CrossRef]
- Unwater. Available online: www.unwater.org/publications/world-water-development-report-2018/ (accessed on 23 June 2024).
- European Enviroment Agency. Available online: https://www.eea.europa.eu/publications/water-resources-across-europe-confronting (accessed on 23 June 2024).
- Issac, M.N.; Kandasubramanian, B. Effect of microplastics in water and aquatic systems. Environ. Sci. Pollut. Res. 2021, 28, 19544–19562. [Google Scholar] [CrossRef] [PubMed]
- Xia, C.; Li, X.; Wu, Y.; Suharti, S.; Unpaprom, Y.; Pugazhendhi, A. A review on pollutants remediation competence of nanocomposites on contaminated water. Environ. Res. 2023, 222, 115318. [Google Scholar] [CrossRef] [PubMed]
- Reliefweb. Available online: https://reliefweb.int/report/world/united-nations-world-water-development-report-2024-water-prosperity-and-peace-enarruzhhiitdeko?gad_source=1&gclid=Cj0KCQjwj9-zBhDyARIsAERjds3Fcqad_EiisivHHnJ24ToL32LD8hl25qkXafxK7etOctY_k-_dhpMaAl0PEALw_wcB (accessed on 23 June 2024).
- Reliefweb. Available online: https://reliefweb.int/report/world/united-nations-world-water-development-report-2023-partnerships-and-cooperation-water-enit?gad_source=1&gclid=Cj0KCQjwj9-zBhDyARIsAERjds0iJRBQNXzTmy9jd_OAX3f78zqUQPzpTFQKU4aw5Cw3VT_ZHWadqpMaAujREALw_wcB (accessed on 23 June 2024).
- Aiken, G.R.; McKnight, D.M.; Wershaw, R.L.; MacCarthy, P. Humic Substances in Soil, Sediment, and Water: Geochemistry, Isolation, and Characterization; John Wiley & Sons, Inc.: Hoboken, NJ, USA, 1985. [Google Scholar] [CrossRef]
- Zularisam, A.W.; Ismail, A.F.; Salim, R. Behaviours of natural organic matter in membrane filtration for surface water treatment—A review. Desalination 2006, 194, 211–231. [Google Scholar] [CrossRef]
- Buccheri, M.A.; D’Angelo, D.; Scalese, S.; Spanò, S.; Filice, S.; Fazio, E.; Compagnini, G.; Zimbone, M.; Brundo, M.; Pecoraro, R.; et al. Modification of graphene oxide by laser irradiation: A new route to enhance antibacterial activity. Nanotechnology 2016, 27, 245704. [Google Scholar] [CrossRef]
- Cruz-Ortiz, B.R.; Hamilton, J.W.J.; Pablos, C.; Díaz-Jiménezò, L.; Cortés-Hernández, D.A.; Sharma, P.K.; Castro-Alférez, M.; Fernández-Ibañez, P.; Dunlop, P.S.M.; Byrne, J.A. Mechanism of photocatalytic disinfection using titania-graphene composites under UV and visible irradiation. Chem. Eng. J. 2017, 316, 179–186. [Google Scholar] [CrossRef]
- Kumar, R.; Qureshi, M.; Kumar Vishwakarma, D.; Al-Ansari, N.; Kuriqi, A.; Elbeltagi, A.; Saraswat, A. A review on emerging water contaminants and the application of sustainable removal technologies. Case Stud. Chem. Environ. Eng. 2022, 6, 100219. [Google Scholar] [CrossRef]
- Alipoori, S.; Rouhi, H.; Linn, E.; Stumpfl, H.; Mokarizadeh, H.; Rabbani Esfahani, M.; Koh, A.; Weinman, S.T.; Wujcik, E.K. Polymer-Based Devices and Remediation Strategies for Emerging Contaminants in Water. ACS Appl. Polym. Mater. 2021, 3, 549–577. [Google Scholar] [CrossRef]
- Zhang, Y.; Vallin, J.R.; Sahoo, J.K.; Gao, F.; Boudouris, B.W.; Webber, M.J.; Phillip, W.A. High-affinity detection and capture of heavy metal contaminants using block polymer composite membranes. ACS Cent. Sci. 2018, 4, 1697–1707. [Google Scholar] [CrossRef] [PubMed]
- Sellami, F.; Kebiche-Senhadji, O.; Marais, S.; Colasse, L.; Fatyeyeva, K. Enhanced removal of Cr (VI) by polymer inclusion membrane based on poly (vinylidene fluoride) and Aliquat. Sep. Purif. Technol. 2020, 248, 117038. [Google Scholar] [CrossRef]
- Padaki, M.; Murali, R.S.; Abdullah, M.S.; Misdan, N.; Moslehyani, A.; Kassim, M.A.; Hilal, N.; Ismail, A.F. Membrane technology enhancement in oil–water separation. A review. Desalination 2015, 357, 197–207. [Google Scholar] [CrossRef]
- Jackson, E.A.; Hillmyer, M.A. Nanoporous Membranes Derived from Block Copolymers: From Drug Delivery to Water Filtration. ACS Nano 2010, 4, 3548–3553. [Google Scholar] [CrossRef] [PubMed]
- Zheng, J.; Chen, C.; Goto, A. Temperature-Directed Micellar Morphological Transformation Using CABC-Block Copolymers and Its Applications in Encap-sulation and Hidden Segment. Angew. Chemie. 2020, 132, 1957–1965. [Google Scholar] [CrossRef]
- Quémener, D.; Deratani, A.; Lecommandoux, S. Dynamic assembly of block–copolymers. In Constitutional Dynamic Chemistry; Springer: Berlin/Heidelberg, Germany, 2011; pp. 165–192. [Google Scholar]
- Wong, C.K.; Qiang, X.; Müller, A.H.E.; Gröschel, A.H. Self-Assembly of block copolymers into internally ordered microparticles. Prog. Polym. Sci. 2020, 102, 101211. [Google Scholar] [CrossRef]
- Radjabian, M.; Abetz, V. Advanced porous polymer membranes from self-assembling block copolymers. Prog. Polym. Sci. 2020, 102, 101219. [Google Scholar] [CrossRef]
- Piñón-Balderrama, C.I.; Leyva-Porras, C.; Conejo-Dávila, A.S.; Zaragoza-Contreras, E.A. Sulfonated Block Copolymers: Synthesis, Chemical Modification, Self-Assembly Morphologies, and Recent Applications. Polymers 2022, 14, 5081. [Google Scholar] [CrossRef]
- Scalese, S.; Nicotera, I.; D’Angelo, D.; Filice, S.; Libertino, S.; Simari, C.; Dimos, K.; Privitera, V. Cationic and anionic azo-dye removal from water by sulfonated graphene oxide nanosheets in Nafion membranes. New J. Chem. 2016, 40, 3654–3663. [Google Scholar] [CrossRef]
- Filice, S.; D’Angelo, D.; Libertino, S.; Nicotera, I.; Kosma, V.; Privitera, V.; Scalese, S. Graphene oxide and titania hybrid Nafion membranes for efficient removal of methyl orange dye from water. Carbon 2015, 82, 489–499. [Google Scholar] [CrossRef]
- Filice, S.; D’Angelo, D.; Scarangella, A.; Iannazzo, D.; Compagnini, G.; Scalese, S. Highly effective and reusable sulfonated pentablock copolymer nanocomposites for water purification applications. RSC Adv. 2017, 7, 45521–45534. [Google Scholar] [CrossRef]
- D’Angelo, D.; Filice, S.; Libertino, S.; Kosma, V.; Nicotera, I.; Privitera, V.; Scalese, S. Photocatalytic properties of Nafion membranes containing graphene oxide/titania nanocomposites. In Proceedings of the 2014 IEEE 9th Nanotechnology Materials and Devices Conference (NMDC), Aci Castello, Italy, 12–15 October 2014; pp. 54–57. [Google Scholar] [CrossRef]
- D’Angelo, D.; Filice, S.; Scarangella, A.; Iannazzo, D.; Compagnini, G.; Scalese, S. Bi2O3/Nexar® polymer nanocomposite membranes for azo dyes removal by UV–vis or visible light irradiation. Catal. Today 2019, 321–322, 158–163. [Google Scholar] [CrossRef]
- Sciuto, E.L.; Filice, S.; Coniglio, M.A.; Faro, G.; Gradon, L.; Galati, C.; Spinella, N.; Libertino, S.; Scalese, S. Antimicrobial s-PBC Coatings for Innovative Multifunctional Water Filters. Molecules 2020, 25, 5196. [Google Scholar] [CrossRef] [PubMed]
- Sciuto, E.L.; Lagana, P.; Filice, S.; Scalese, S.; Libertino, S.; Corso, D.; Faro, G.; Coniglio, M.A. Environmental Management of Legionella in Domestic Water Systems: Consolidated and Innovative Approaches for Disinfection Methods and Risk Assessment. Microorganisms 2021, 9, 577. [Google Scholar] [CrossRef] [PubMed]
- Peddinti, B.S.T.; Scholle, F.; Vargas, M.G.; Smith, S.D.; Ghiladi, R.A.; Spontak, R.J. Inherently self-sterilizing charged multiblock polymers that kill drug-resistant microbes in minutes. Mater. Horiz. 2019, 6, 2056–2062. [Google Scholar] [CrossRef]
- Xu, X.; Yang, Y.; Liu, T.; Chu, B. Cost-effective polymer-based membranes for drinking water purification. Giant 2022, 10, 100099. [Google Scholar] [CrossRef]
- Lyman, D.J. Investigation of synthetic membranes for hemodialysis. Trans.-Am. Soc. Artif. Intern. Organs 1963, 9, 92–96. [Google Scholar]
- Lyman, D.J.; Loo, B.H.; Crawford, R.W. New synthetic membranes for dialysis. I. A copolyether-ester membrane system. Biochemistry 1964, 3, 985–990. [Google Scholar] [CrossRef]
- John, R.; Pal, K.; Jayan, J.S.; Appukuttan, S.; Joseph, K. New emerging review on advances in block copolymer based water purification membranes. J. Mol. Struct. 2021, 1231, 129926. [Google Scholar] [CrossRef]
- Werber, J.; Osuji, C.; Elimelech, M. Materials for next-generation desalination and water purification membranes. Nat. Rev. Mater. 2016, 1, 16018. [Google Scholar] [CrossRef]
- Gu, Y.; Wiesner, U. Tailoring pore size of graded mesoporous block copolymer membranes: Moving from ultrafiltration toward nanofiltration. Macromolecules 2015, 48, 6153–6159. [Google Scholar] [CrossRef]
- Mulvenna, R.A.; Weidman, J.L.; Jing, B.; Pople, J.A.; Zhu, Y.; Boudouris, B.W.; Phillip, W.A. Tunable nanoporous membranes with chemically-tailored pore walls from triblock polymer templates. J. Membr. Sci. 2014, 470, 246–256. [Google Scholar] [CrossRef]
- Zhang, Z.; Rahman, M.M.; Abetz, C.; Bajer, B.; Wang, J.; Abetz, V. Quaternization of a polystyrene-block-poly(4-vinylpyridine) isoporous membrane: An approach to tune the pore size and the charge density. Macromol. Rapid Commun. 2019, 40, 1800729. [Google Scholar] [CrossRef] [PubMed]
- Piñón-Balderrama, C.; Leyva-Porras, C.; Olayo-Valles, R.; Revilla-Vázquez, J.; Schubert, U.S.; Guerrero-Sanchez, C.; Bonilla-Cruz, J. Self-Assembly Investigations of Sulfonated Poly(Methyl Methacrylate-Block-Styrene) Diblock Copolymer Thin Films. Adv. Polym. Technol. 2019, 2019, 4375838. [Google Scholar] [CrossRef]
- Fredrickson, G.H.; Eugene, H. Fluctuation Effects in the Theory of Microphase Separation in Block Copolymers. J. Chem. Phys. 1987, 87, 697–705. [Google Scholar] [CrossRef]
- Mariani, M.; Lelli, M.; Sparnacci, K.; Laus, M. Diblock and triblock functional copolymers by controlled radical polymerization. J. Polym. Sci. Part A Polym. Chem. 2020, 37, 1237–1244. [Google Scholar] [CrossRef]
- Kong, H.; Li, W.; Gao, C.; Yan, D.; Jin, Y.; Walton, D.R.M.; Kroto, H.W. Poly(N-isopropylacrylamide)-Coated Carbon Nanotubes: Temperature-Sensitive Molecular Nanohybrids. Water. Macromol. 2004, 37, 6683–6686. [Google Scholar] [CrossRef]
- Mai, Y.; Eisenberg, A. Self-assembly of block copolymers. Chem. Soc. Rev. 2012, 41, 5969–5985. [Google Scholar] [CrossRef]
- Tsaur, L.; Wiesner, U.B. Non-Equilibrium Block Copolymer Self-Assembly Based Porous Membrane Formation Processes Employing Multicomponent Systems. Polymers 2023, 15, 2020. [Google Scholar] [CrossRef]
- Nunes, S.P. Block Copolymer Membranes for Aqueous Solution Applications. Macromolecules 2016, 49, 2905–2916. [Google Scholar] [CrossRef]
- Cooney, D.T.; Hillmyer, M.A.; Cussler, E.L.; Moggridge, G.D. Diffusion in nanoporous materials made from block copolymers. Crystallogr. Rev. 2006, 12, 13–24. [Google Scholar] [CrossRef]
- Phillip, W.A.; Rzayev, J.; Hillmyer, M.A.; Cussler, E.L. Gas and water liquid transport through nanoporous block copolymer membranes. J. Membr. Sci. 2006, 286, 144–152. [Google Scholar] [CrossRef]
- Phillip, W.A.; Amendt, M.; O’Neill, B.; Chen, L.; Hillmyer, M.A.; Cussler, E.L. Diffusion and Flow Across Nanoporous Polydicyclopentadiene-Based Membranes. ACS Appl. Mater. Interfaces 2009, 1, 472–480. [Google Scholar] [CrossRef] [PubMed]
- Wandera, D.; Himstedt, H.H.; Marroquin, M.; Wickramasinghe, S.R.; Husson, S.M. Modification of ultrafiltration membranes with block copolymer nanolayers for produced water treatment: The roles of polymer chain density and polymerization time on performance. J. Membr. Sci. 2012, 403–404, 250–260. [Google Scholar] [CrossRef]
- Schacher, F.; Ulbricht, M.; Müller, A.H.E. Self-Supporting, Double Stimuli-Responsive Porous Membranes From Polystyrene-block-poly(N,N-dimethylaminoethyl methacrylate) Diblock Copolymers. Adv. Funct. Mater. 2009, 19, 1040–1045. [Google Scholar] [CrossRef]
- Nunes, S.P.; Behzad, A.R.; Hooghan, B.; Sougrat, R.; Karunakaran, M.; Pradeep, N.; Vainio∥, U.; Peinemann, K.V. Switchable pH-Responsive Polymeric Membranes Prepared via Block Copolymer Micelle Assembly. ACS Nano 2011, 5, 3516–3522. [Google Scholar] [CrossRef] [PubMed]
- Phillip, W.A.; O’Neill, B.; Rodwogin, M.; Hillmyer, M.A.; Cussler, E.L. Self-Assembled Block Copolymer Thin Films as Water Filtration Membranes. Appl. Mater. Interfaces 2010, 2, 847–853. [Google Scholar] [CrossRef] [PubMed]
- Agustina, S.; Tokuda, M.; Minami, H.; Boyer, C.; Zetterlund, P.B. Synthesis of polymeric nano-objects of various morphologies based on block copolymer self-assembly using microporous membranes† Check for updates. React. Chem. Eng. 2017, 2, 451–457. [Google Scholar] [CrossRef]
- Zhao, Y.F.; Zhu, L.P.; Yi, Z.; Zhu, B.K.; Xu, Y.Y. Improving the hydrophilicity and fouling-resistance of polysulfone ultrafiltration membranes via surface zwitterionicalization mediated by polysulfone-based triblock copolymer additive. J. Membr. Sci. 2013, 440, 40–47. [Google Scholar] [CrossRef]
- Ganwei, Z.; Renbi, B.; Shusu, S.; Xiaoji, Z.; Yongfu, G. Hydrophilic and photo-crosslinkable diblock copolymers employed for robust antifouling membrane coatings. Appl. Surf. Sci. 2019, 464, 429–439. [Google Scholar] [CrossRef]
- Rajasekhar, T.; Trinadh, M.; Babu, P.V.; Sainath, A.V.S.; Reddy, A.V.R. Oil–water emulsion separation using ultrafiltration membranes based on novel blends of poly(vinylidene fluoride) and amphiphilic tri-block copolymer containing carboxylic acid functional group. J. Membr. Sci. 2015, 481, 82–93. [Google Scholar] [CrossRef]
- Gore, S.; Rane, K. Studying the Effect of Cross-Linking and Sulfonation on the Calcium-Binding Ability of Polystyrene Sulfonate in the Presence of Dodecyl Sulfate. Ind. Eng. Chem. Res. 2023, 62, 7017–7030. [Google Scholar] [CrossRef]
- Kučera, F.; Jančář, J. Homogeneous and Heterogeneous Sulfonation of Polymers: A Review. Polym. Eng. Sci. 1998, 38, 783–792. [Google Scholar] [CrossRef]
- Cerfontain, H.; Hofman, H.J.; Telder, A. Aromatic sulfonation: Determination of the kinetic isotope effect of hydrogen in the sulfonation and sulfonylation of benzene remarks on hydrogen exchange between benzene and benzenesulfonic acid. Rec. Trav. Chim. 1964, 83, 493. [Google Scholar] [CrossRef]
- Chen, S.L.; Krishnan, L.; Srinivasan, S.; Benziger, J.; Bocarsly, A.B. Ion exchange resin/polystyrene sulfonate composite membranes for PEM fuel cells. J. Membr. Sci. 2004, 243, 327–333. [Google Scholar] [CrossRef]
- Khomein, P.; Liu, G. Front Matter. In Industrial Arene Chemistry; Mortier, J., Ed.; Wiley: Hoboken, NJ, USA, 2023. [Google Scholar] [CrossRef]
- Sang, S.; Wang, S.; Yang, C.; Geng, Z.; Zhang, X. Sponge-Inspired Sulfonated Polyetheretherketone Loaded with Polydopamine-Protected Osthole Nanoparticles and Berberine Enhances Osteogenic Activity and Prevents Implant-Related Infections. Chem. Eng. J. 2022, 437, 135255. [Google Scholar] [CrossRef]
- Huang, Z.; Lv, B.; Zhou, L.; Qin, X.; Shao, Z. Ultra-Thin h-BN Doped High Sulfonation Sulfonated Poly (Ether-Ether-Ketone) of PTFE-Reinforced Proton Exchange Membrane. J. Memb. Sci. 2022, 644, 120099. [Google Scholar] [CrossRef]
- Storey, R.F.; George, S.E.; Nelson, M.E. Star-Branched Block Copolymer Ionomers. Synthesis, Characterization, and Properties. Macromolecules 1991, 24, 2920–2930. [Google Scholar] [CrossRef]
- Erdogan, T.; Unveren, E.E.; Inan, T.Y.; Birkan, B. Well-Defined Block Copolymer Ionomers and Their Blend Membranes for Proton Exchange Membrane Fuel Cell. J. Memb. Sci. 2009, 344, 172–181. [Google Scholar] [CrossRef]
- Tsang, E.M.W.; Shi, Z.; Holdcroft, S. Ionic Purity and Connectivity of Proton-Conducting Channels in Fluorous-Ionic Diblock Copolymers. Macromolecules 2011, 44, 8845–8857. [Google Scholar] [CrossRef]
- Ruiz-Colón, E.; Pérez-Pérez, M.; Suleiman, D. Synthesis and Characterization of Novel Phosphonated and Sulfonated Poly(Styrene–Isobutylene–Styrene) for Fuel Cell and Protective Clothing Applications. J. Polym. Sci. Part A Polym. Chem. 2018, 56, 1424–1435. [Google Scholar] [CrossRef]
- Noshay, A.; Robeson, L.M. Sulfonated Polysulfone. J. Appl. Polym. Sci. 1976, 20, 1885–1903. [Google Scholar] [CrossRef]
- Gatsouli, K.D.; Pispas, S.; Kamitsos, E.I. Development and Optical Properties of Cadmium Sulfide and Cadmium Selenide Nanoparticles in Amphiphilic Block Copolymer Micellar-like Aggregates. J. Phys. Chem. C 2007, 111, 15201–15209. [Google Scholar] [CrossRef]
- Politakos, N.; Moutsios, I.; Manesi, G.M.; Artopoiadis, K.; Tsitoni, K.; Moschovas, D.; Piryazev, A.A.; Kotlyarskiy, D.S.; Kortaberria, G.; Ivanov, D.A.; et al. Molecular and Structure–Properties Comparison of an Anionically Synthesized Diblock Copolymer of the PS-b-PI Sequence and Its Hydrogenated or Sulfonated Derivatives. Polymers 2021, 13, 4167. [Google Scholar] [CrossRef] [PubMed]
- Liang, L.; Ying, S. Charge-mosaic Membrane from Gamma-irradiated Poly(Styrene-butadiene-4-vinylpyridine) Triblock Copolymer. J. Polym. Sci. Part B Polym. Phys. 1993, 31, 1075–1081. [Google Scholar] [CrossRef]
- Xu, K.; Li, K.; Khanchaitit, P.; Wang, Q. Synthesis and Characterization of Self-Assembled Sulfonated Poly (Styrene-b-Vinylidene Fluoride-b-Styrene) Triblock Copolymers for Proton Conductive Membranes. Chem. Mater. 2007, 19, 5937–5945. [Google Scholar] [CrossRef]
- Yang, J.C.; Mays, J.W. Synthesis and Characterization of Neutral/Ionic Block Copolymers of Various Architectures. Macromolecules 2002, 35, 3433–3438. [Google Scholar] [CrossRef]
- Yang, X.; Kim, J.H.; Kim, Y.J. Enhanced Proton Conductivity of Poly(Ether Sulfone) Multi-Block Copolymers Grafted with Densely Pendant Sulfoalkoxyl Side Chains for Proton Exchange Membranes. Polymer 2022, 242, 124604. [Google Scholar] [CrossRef]
- Loveday, D.; Wilkes, G.L.; Deporter, C.D.; McGrath, J.E. Structure and Properties of Butadiene–Tert-Butyl Methacrylate and Butadiene/Styrene–Tert-Butyl Methacrylate Triblock Copolymer Ionomers. Macromolecules 1995, 28, 7822–7830. [Google Scholar] [CrossRef]
- Yeo, J.; Kim, S.Y.; Kim, S.; Ryu, D.Y.; Kim, T.H.; Park, M.J. Mechanically and structurally robust sulfonated block copolymer membranes for water purification applications. Nanotechnology 2012, 23, 245703. [Google Scholar] [CrossRef]
- Kim, J.H.; Kim, J.W.; Shokouhimehr, M.; Lee, Y.S. Polymer-Supported N-Heterocyclic Carbene-Palladium Complex for Heterogeneous Suzuki Cross-Coupling Reaction. J. Org. Chem. 2005, 70, 6714–6720. [Google Scholar] [CrossRef] [PubMed]
- Gu, Y.; Lodge, T.P. Synthesis and Gas Separation Performance of Triblock Copolymer Ion Gels with a Polymerized Ionic Liquid Mid-Block. Macromolecules 2011, 44, 1732–1736. [Google Scholar] [CrossRef]
- Tang, J.; Tang, H.; Sun, W.; Plancher, H.; Radosz, M.; Shen, Y. Poly (Ionic Liquid)s: A New Material with Enhanced and Fast CO2 Absorption. Chem. Commun. 2005, 26, 3325–3327. [Google Scholar] [CrossRef]
- Miyahara, T.; Hayano, T.; Matsuno, S.; Watanabe, M.; Miyatake, K. Sulfonated Polybenzophenone/Poly (Arylene Ether) Block Copolymer Membranes for Fuel Cell Applications. ACS Appl. Mater. Interfaces 2012, 4, 2881–2884. [Google Scholar] [CrossRef] [PubMed]
- Armand, M.; Endres, F.; MacFarlane, D.R.; Ohno, H.; Scrosati, B. Ionic-Liquid Materials for the Electrochemical Challenges of the Future. Nat. Mater. 2009, 8, 621–629. [Google Scholar] [CrossRef] [PubMed]
- Young, W.S.; Kuan, W.F.; Epps, T.H. Block Copolymer Electrolytes for Rechargeable Lithium Batteries. J. Polym. Sci. Part B Polym. Phys. 2014, 52, 1–16. [Google Scholar] [CrossRef]
- Wijaya, F.; Woo, S.; Lee, H.; Nugraha, A.F.; Shin, D.; Bae, B. Sulfonated Poly(Phenylene-Co-Arylene Ether Sulfone) Multiblock Membranes for Application in High-Performance Fuel Cells. J. Memb. Sci. 2022, 645, 120203. [Google Scholar] [CrossRef]
- Meier-Haack, J.; Taeger, A.; Vogel, C.; Schlenstedt, K.; Lenk, W.; Lehmann, D. Membranes from Sulfonated Block Copolymers for Use in Fuel Cells. Sep. Purif. Technol. 2005, 41, 207–220. [Google Scholar] [CrossRef]
- Rubatat, L.; Li, C.; Nyka, A.; Ruokolainen, J. Structure—Properties Relationship in Proton Conductive Sulfonated Polystyrene—Polymethyl Methacrylate Block Copolymers (SPS—PMMA). Macromolecules 2008, 41, 8130–8137. [Google Scholar] [CrossRef]
- Mineart, K.P.; Dickerson, J.D.; Love, D.M.; Lee, B.; Zuo, X.; Spontak, R.J. Hydrothermal Conditioning of Physical Hydrogels Prepared from a Midblock-Sulfonated Multiblock Copolymer. Macromol. Rapid Commun. 2017, 38, 1600666. [Google Scholar] [CrossRef]
- Sing, C.E.; Zwanikken, J.W.; Olvera De La Cruz, M. Electrostatic Control of Block Copolymer Morphology. Nat. Mater. 2014, 13, 694–698. [Google Scholar] [CrossRef] [PubMed]
- Landim, A.; Rodrigues Filho, G.; De Assunção, R. Use of polystyrene sulfonate produced from waste plastic cups as an auxiliary agent of coagulation, flocculation and flotation for water and wastewater treatment in Municipal Department of Water and Wastewater in Uberlândia-MG, Brazil. Polym. Bull. 2007, 58, 457–463. [Google Scholar] [CrossRef]
- Filice, S.; Urzì, G.; Milazzo, R.G.; Privitera, S.M.S.; Lombardo, S.A.; Compagnini, G.; Scalese, S. Applicability of a New Sulfonated Pentablock Copolymer Membrane and Modified Gas Diffusion Layers for Low-Cost Water Splitting Processes. Energies 2019, 12, 2064. [Google Scholar] [CrossRef]
- Willis, L.; Handlin, V.; Trenor, S.R.; Mather, B.D. Sulfonated Block Copolymers, Method for Making Same, and Various Uses for Such Block Copolymers. U.S. Patent 7,737,224 B2, 15 June 2010. [Google Scholar]
- Geise, G.M.; Freeman, B.D.; Paul, D.R. Characterization of a sulfonated pentablock copolymer for desalination applications. Polymer 2010, 51, 5815–5822. [Google Scholar] [CrossRef]
- Geise, G.M.; Falcon, L.P.; Freeman, B.D.; Paul, D.R. Sodium chloride sorption in sulfonated polymers for membrane applications. J. Membr. Sci. 2013, 423–424, 195–208. [Google Scholar] [CrossRef]
- Fan, Y.; Zhang, M.; Moore, R.B.; Cornelius, C.J. Structure, physical properties, and molecule transport of gas, liquid, and ions within a pentablock copolymer. J. Membr. Sci. 2014, 464, 179–187. [Google Scholar] [CrossRef]
- Choi, J.H.; Willis, C.L.; Winey, K.I. Structure-Property Relationship in Sulfonated Pentablock Copolymers. J. Membr. Sci. 2012, 394–395, 169–174. [Google Scholar] [CrossRef]
- Choi, J.H.; Willis, C.L.; Winey, K.I. Effects of Neutralization with Et3Al on Structure and Properties in Sulfonated Styrenic Pentablock Copolymers. J. Membr. Sci. 2013, 428, 516–522. [Google Scholar] [CrossRef]
- Mineart, K.P.; Jiang, X.; Jinnai, H.; Takahara, A.; Spontak, R.J. Morphological Investigation of Midblock-Sulfonated Block Ionomers Prepared from Solvents Differing in Polarity. Macromol. Rapid Commun. 2015, 36, 432–438. [Google Scholar] [CrossRef]
- Choi, J.-H.; Kota, A.; Winey, K.I. Micellar Morphology in Sulfonated Pentablock Copolymer Solutions. Ind. Eng. Chem. Res. 2010, 49, 12093–12097. [Google Scholar] [CrossRef]
- Truong, P.V.; Black, R.L.; Coote, J.P.; Lee, B.; Ardebili, H.; Stein, G.E. Systematic Approaches To Tailor the Morphologies and Transport Properties of Solution-Cast Sulfonated Pentablock Copolymers. ACS Appl. Polym. Mater. 2019, 1, 8–17. [Google Scholar] [CrossRef]
- Truong, P.V.; Shingleton, S.; Kammoun, M.; Black, R.L.; Charendoff, M.; Willis, C.; Ardebili, H.; Stein, G.E. Structure and Properties of Sulfonated Pentablock Terpolymer Films as a Function of Wet–Dry Cycles. Macromolecules 2018, 51, 2203–2215. [Google Scholar] [CrossRef]
- Rahimpour, S.; Madaeni, S.; Taheri, A.H.; Mansourpanah, V. Coupling TiO2 nanoparticles with UV irradiation for modification of polyethersulfone ultrafiltration membranes. J. Membr. Sci. 2008, 313, 158–169. [Google Scholar] [CrossRef]
- Damodar, R.A.; You, S.J.; Chou, H.H. Study the self cleaning, antibacterial and photocatalytic properties of TiO2 entrapped PVDF membranes. J. Hazard. Mater. 2009, 172, 1321–1328. [Google Scholar] [CrossRef] [PubMed]
- Zhao, X.; Zhang, R.; Liu, Y.; He, M.; Su, Y.; Gao, C.; Jiang, Z. Antifouling membrane surface construction: Chemistry plays a critical role. J. Membr. Sci. 2018, 551, 145–171. [Google Scholar] [CrossRef]
- Petronella, F.; Truppi, A.; Ingrosso, C.; Placido, T.; Striccoli, V.; Curri, M.L.; Agostiano, A.; Comparelli, R. Nanocomposite materials for photocatalytic degradation of pollutants. Catal. Today 2017, 281, 85–100. [Google Scholar] [CrossRef]
- Filice, S.; Mazurkiewicz-Pawlicka, M.; Malolepszy, A.; Stobinski, L.; Kwiatkowski, R.; Boczkowska, A.; Gradon, L.; Scalese, S. Sulfonated Pentablock Copolymer Membranes and Graphene Oxide Addition for Efficient Removal of Metal Ions from Water. Nanomaterials 2020, 10, 1157. [Google Scholar] [CrossRef] [PubMed]
- Jain, A.; Weathers, C.; Kim, J.; Meyer, M.D.; Walker, W.S.; Li, Q.; Verduzco, R. Self assembled, sulfonated pentablock copolymer cation exchange coatings for membrane capacitive deionization. Mol. Syst. Des. Eng. 2019, 4, 348–356. [Google Scholar] [CrossRef]
- Zuo, J.; Shi, G.M.; Wei, S.; Chung, T.S. The Development of Novel Nexar Block Copolymer/Ultem Composite Membranes for C2–C4 Alcohols Dehydration via Pervaporation. ACS Appl. Mater. Interfaces 2014, 6, 13874–13883. [Google Scholar] [CrossRef]
- Shi, G.M.; Zuo, J.; Tang, S.H.; Wei, S.; Chung, T.S. Layer-by-layer (LbL) polyelectrolyte membrane with NexarTM polymer as a polyanion for pervaporation dehydration of ethanol. Sep. Purif. Technol. 2015, 140, 13–22. [Google Scholar] [CrossRef]
- Thomas, E.R.; Jain, A.; Mann, S.C.; Yang, Y.; Green, M.D.; Walker, W.S.; Perreault, F.; Lind, M.L.; Verduzco, R. Freestanding self-assembled sulfonated pentablock terpolymer membranes for high flux pervaporation desalination. J. Membr. Sci. 2020, 613, 118460. [Google Scholar] [CrossRef]
- Thomas, E.R.; Lee, J.S.; Behbahani, H.S.; Nazari, A.; Li, Y.; Yang, Y.; Green, M.D.; Lind, M.L. Zwitterionic Copolymers for Anti-Scaling Applications in Simulated Spaceflight Wastewater Scenarios. ACS Omega 2023, 8, 18462–18471. [Google Scholar] [CrossRef] [PubMed]
- Qu, J. Research progress of novel adsorption processes in water purification: A review. J. Environ. Sci. 2008, 20, 1–13. [Google Scholar] [CrossRef]
- Singh, N.B.; Nagpal, G.; Rachna, S.A. Water purification by using Adsorbents: A Review. Environ. Technol. Innov. 2018, 11, 187–240. [Google Scholar] [CrossRef]
- Choi, W.S.; Lee, H.J. Nanostructured Materials for Water Purification: Adsorption of Heavy Metal Ions and Organic Dyes. Polymers 2022, 14, 2183. [Google Scholar] [CrossRef] [PubMed]
- Thong, Z.; Han, G.; Cui, Y.; Gao, J.; Chung, T.S.; Chan, S.Y.; Wei, S. Novel Nanofiltration Membranes Consisting of a Sulfonated Pentablock Copolymer Rejection Layer for Heavy Metal Removal. Environ. Sci. Technol. 2014, 48, 13880–13887. [Google Scholar] [CrossRef] [PubMed]
- Kraton. Available online: https://kraton.com/shared_file/88570/ (accessed on 25 June 2024).
- Zhao, G.; Li, J.; Ren, X.; Chen, C.; Wang, X. Few-layered Graphene Oxide nanosheets as superior sorbents for heavy metal ion pollution management. Environ. Sci. Technol. 2011, 45, 10454–10462. [Google Scholar] [CrossRef] [PubMed]
- Muthukrishnaraj, A.; Manokaran, J.; Vanitha, M.; Thiruvengadaravi, K.V.; Baskaralingam, P.; Balasubramanian, N. Equilibrium, kinetic and thermodynamic studies for the removal of Zn(II) and Ni(II) ions using magnetically recoverable graphene/Fe3O4 composite. Desalin. Water Treat. 2014, 56, 2485–2501. [Google Scholar] [CrossRef]
- Fan, L.; Luo, C.; Sun, M.; Li, X.; Qiu, H. Highly selective adsorption of Pb ions by water-dispersible magnetic chitosan/graphene oxide composites. Colloid Surf. B 2013, 103, 523–529. [Google Scholar] [CrossRef]
- Chella, S.; Kollu, P.; Komarala, E.V.P.R.; Doshi, S.; Saranya, M.; Felix, S.; Ramachandran, R.; Saravanan, P.; Koneru, V.L.; Venugopal, V.; et al. Solvothermal synthesis of MnFe2O4-graphene composite—Investigation of its adsorption and antimicrobialproperties. Appl. Surf. Sci. 2015, 327, 27–36. [Google Scholar] [CrossRef]
- Mamun, A.A.; Ahmed, Y.M.; AlKhatib, M.F.R.; Jameel, A.T.; Mahar, A. Lead sorption by carbon nanofibers grown on powdered activated carbon—Kinetics and equilibrium. Nano 2015, 10, 1550017. [Google Scholar] [CrossRef]
- Nasef, M.M.; Yahaya, A.H. Adsorption of some heavy metal ions from aqueous solutions on Nafion 117 membrane. Desalination 2009, 249, 677–681. [Google Scholar] [CrossRef]
- Filice, S.; Bongiorno, C.; Libertino, S.; Compagnini, G.; Gradon, L.; Iannazzo, D.; La Magna, A.; Scalese, S. Structural Characterization and Adsorption Properties of Dunino Raw Halloysite Mineral for Dye Removal from Water. Materials 2021, 14, 3676. [Google Scholar] [CrossRef] [PubMed]
- Filice, S.; Bongiorno, C.; Libertino, S.; Gradon, L.; Iannazzo, D.; Scalese, S. Photo-Fenton Degradation of Methyl Orange with Dunino Halloysite as a Source of Iron. Catalysts 2022, 12, 257. [Google Scholar] [CrossRef]
- Rehman, K.; Shahzad, T.; Sahar, A.; Hussain, S.; Mahmood, F.; Siddique, M.H.; Siddique, M.A.; Rashid, M.I. Effect of Reactive Black 5 azo dye on soil processes related to C and N cycling. PeerJ 2018, 6, 4802. [Google Scholar] [CrossRef] [PubMed]
- Imran, M.; Crowley, D.E.; Khalid, A.; Hussain, S.; Mumtaz, M.W.; Arshad, M. Microbial biotechnology for decolorization of textile wastewaters. Rev. Environ. Sci. Biotechnol. 2015, 14, 73–92. [Google Scholar] [CrossRef]
- Khan, S.; Malik, A. Toxicity evaluation of textile effluents and role of native soil bacterium in biodegradation of a textile dye. Environ. Sci. Pollut. Res. 2018, 25, 4446–4458. [Google Scholar] [CrossRef] [PubMed]
- Copaciu, F.; Opriş, O.; Coman, V.; Ristoiu, D.; Niinemets, U.; Copolovici, L. Diffuse Water Pollution by Anthraquinone and Azo Dyes in Environment Importantly Alters Foliage Volatiles, Carotenoids and Physiology in Wheat (Triticum aestivum). Water Air Soil Pollut. 2013, 224, 1478. [Google Scholar] [CrossRef]
- Ma, D.; Yi, H.; Lai, C.; Liu, X.; Huo, X.; An, Z.; Li, L.; Fu, Y.; Li, B.; Zhang, M.; et al. Critical review of advanced oxidation processes in organic wastewater treatment. Chemosphere 2021, 275, 130104. [Google Scholar] [CrossRef]
- Kumari, P.; Kumar, A. Advanced oxidation process: A remediation technique for organic and non-biodegradable pollutant. Results Surf. Interfaces 2023, 11, 100122. [Google Scholar] [CrossRef]
- Goodarzi, N.; Ashrafi-Peyman, Z.; Khani, E.; Moshfegh, A.Z. Recent Progress on Semiconductor Heterogeneous Photocatalysts in Clean Energy Production and Environmental Remediation. Catalysts 2023, 13, 1102. [Google Scholar] [CrossRef]
- Puri, N.; Gupta, A. Water remediation using titanium and zinc oxide nanomaterials through disinfection and photo catalysis process: A review. Environ. Res. 2023, 227, 115786. [Google Scholar] [CrossRef] [PubMed]
- Dong, S.; Fenga, J.; Fan, M.; Pia, Y.; Hua, L.; Hana, X.; Liua, M.; Sun, J.; Sun, J. Recent developments in heterogeneous photocatalytic water treatment using visible light-responsive photocatalysts: A review. RSC Adv. 2015, 5, 14610–14630. [Google Scholar] [CrossRef]
- Huang, S.M.; Weng, C.H.; Tzeng, J.H.; Huang, Y.Z.; Anotai, J.; Yen, L.T.; Chang, C.J.; Lin, Y.T. Kinetic study and performance comparison of TiO2-mediated visible-light-responsive photocatalysts for the inactivation of Aspergillus niger. Sci. Total Environ. 2019, 692, 975–983. [Google Scholar] [CrossRef] [PubMed]
- Wells, K.M.; Miller, M.M.; Ghiladi, R.A.; Spontak, R.J. Fast Bacterial Inactivation Kinetics on an Inherently Antimicrobial Anionic Block Polymer. ACS Appl. Eng. Mater. 2023, 1, 1467–1472. [Google Scholar] [CrossRef]
- Filice, S.; Sciuto, E.L.; Scalese, S.; Faro, G.; Libertino, S.; Corso, D.; Timpanaro, R.M.; Laganà, P.; Coniglio, M.A. Innovative Antibiofilm Smart Surface against Legionella for Water Systems. Microorganisms 2022, 10, 870. [Google Scholar] [CrossRef] [PubMed]
- Filice, S.; Scuderi, V.; Libertino, S.; Zimbone, M.; Galati, C.; Spinella, N.; Gradon, L.; Falqui, L.; Scalese, S. Sulfonated Pentablock Copolymer Coating of Polypropylene Filters for Dye and Metal Ions Effective Removal by Integrated Adsorption and Filtration Process. Int. J. Mol. Sci. 2022, 23, 11777. [Google Scholar] [CrossRef] [PubMed]
- Filice, S.; Scuderi, V.; Zimbone, M.; Libertino, S.; La Piana, L.; Farina, R.A.; Scalese, S. Sulfonated Pentablock Copolymer with Graphene Oxide for Co2+ Ions Removal: Efficiency, Interaction Mechanisms and Secondary Reaction Products. Coatings 2023, 13, 1715. [Google Scholar] [CrossRef]
- Peeva, P.D.; Knoche, T.; Pieper, T.; Ulbricht, M. Cross-flow ultrafiltration of protein solutions through unmodified and surface functionalized polyethersulfone membranes—Effect of process conditions on separation performance. Sep. Purif. Technol. 2012, 92, 83–92. [Google Scholar] [CrossRef]
- Ng, L.Y.; Ahmad, A.; Mohammad, A.W. Alteration of polyethersulphone membranes through UV-induced modification using various materials: A brief review. Arab. J. Chem. 2017, 10, S1821–S1834. [Google Scholar] [CrossRef]
- Jaganathan, S.K.; Balaji, A.; Vellayappan, M.V.; Subramanian, A.P.; John, A.A.; Asokan, M.K.; Supriyanto, E. Review: Radiation-induced surface modification of polymers for biomaterial application. J. Mater. Sci. 2015, 50, 2007–2018. [Google Scholar] [CrossRef]
- Le, Q.T.; Naumov, S.; Conard, T.; Franquet, A.; Müller, M.; Beckhoff, B.; Adelmann, C.; Struyf, H.; De Gendt, S.; Baklanov, M.R. Mechanism of modification of fluorocarbon polymer by ultraviolet irradiation in oxygen atmosphere. ECS J. Solid State Sci. Technol. 2013, 2, N93. [Google Scholar]
- Ramanathan, R.; Kessler, F.; de Mour Leal, P.H.; Kühn, S.; Weibel, D.E. Surface modification of synthetic polymers using UV photochemistry in the presence of reactive vapours. Macromol. Symp. 2011, 299–300, 175–182. [Google Scholar] [CrossRef]
- Ansari, M.Y.; Rizvi, S.J.A.; Inamuddin. Preparation and Properties of Novel Sulfonated Pentablock Copolymer (sPBC) Membrane for PEM Fuel Cell. In Smart Innovation, Systems and Technologies, Proceedings of the International Conference in Mechanical and Energy Technology, Greater Noida, India, 7–8 November 2020; Yadav, S., Singh, D., Arora, P., Kumar, H., Eds.; Springer: Singapore, 2020; Volume 174. [Google Scholar] [CrossRef]
- Ansari, M.Y.; Ansari, K.B.; Inamuddin; Rizvi, S.J.A. Investigating the performance of functionalized and pristine graphene oxide impregnated NexarTM nanocomposite membranes for PEM fuel cell. Chem. Eng. J. Adv. 2022, 11, 100346. [Google Scholar] [CrossRef]
- Ansari, M.Y.; Ansari, K.B.; Inamuddin; Rizvi, S.J.A. Silica and Sulfonated Silica Functionalized Nexar Nanocomposite Membranes for Application in Proton Exchange Membrane Fuel Cell. Arab. J. Sci. Eng. 2023, 48, 16187–16199. [Google Scholar] [CrossRef]
- Hwang, M.; Nixon, K.; Sun, R.; Willis, C.; Elabd, Y. Sulfonated pentablock terpolymers as membranes and ionomers in hydrogen fuel cells. J. Membr. Sci. 2021, 633, 119330. [Google Scholar] [CrossRef]
- Huang, F.; Largier, T.D.; Zheng, W.; Cornelius, C.J. Pentablock copolymer morphology dependent transport and its impact upon film swelling, proton conductivity, hydrogen fuel cell operation, vanadium flow battery function, and electroactive actuator performance. J. Membr. Sci. 2018, 545, 1–10. [Google Scholar] [CrossRef]
- Fan, Y.; Cornelius, C. Raman Spectroscopic and Gas Transport Study of a Pentablock Ionomer Complexed with Metal Ions and Its Relationship to Physical Properties. J. Mater. Sci. 2014, 48, 1153–1161. [Google Scholar] [CrossRef]
- Dai, Z.; Ansaloni, L.; Ryan, J.J.; Spontak, R.J.; Deng, L. Incorporation of an ionic liquid into a midblock-sulfonated multiblock polymer for CO2 capture. J. Membr. Sci. 2019, 588, 117193. [Google Scholar] [CrossRef]
- Yang, Y.; Tocchetto, R.; Nixon, K.; Sun, R.; Elabd, Y.A. Dehumidification via polymer electrolyte membrane electrolysis with sulfonated pentablock terpolymer. J. Membr. Sci. 2022, 658, 120709. [Google Scholar] [CrossRef]
- Upadhyaya, L.; Gebreyohannes, A.Y.; Akhtar, F.H.; Falca, G.; Musteata, V.; Mahalingam, D.K.; Almansoury, R.; Ng, K.C.; Nunes, S.P. NEXARTM-coated hollow fibers for air dehumidification. J. Membr. Sci. 2020, 614, 118450. [Google Scholar] [CrossRef]

| Pollutants | Sources | Effects | Remediations |
|---|---|---|---|
| Organic pollutants | Natural organic matter, Industrial waste (dyes, pesticides, chlorinated compounds, pharmaceuticals) | Mutagenicity, pH, COD, | Coagulation, membrane filtration, ion exchange/adsorption, ozonation/biodegradation, UV/Vis photocatalysis |
| Inorganic pollutants | Soil-erosion, power plants (Metals/Metalloids, nitrates, phosphates) | Acidity, hardness, | Adsorption, chemical precipitation, coagulation, flocculation, ion exchange, and membrane filtration |
| Microorganisms | Sewage, animal excrement (E. coli, Bacillus subtilis, Pseudomonas aeruginosa, Enterococcus faecalis, Giardia lamblia) | Waterborne disease | Halogenated compounds Disinfection compounds UV light UV/Vis photocatalysis |
| Emerging contaminants | Synthetic Natural New pathogens | Deleterious effects on endocrine systems and thyroid gland, infertility, cancer | Coagulation Flocculation membrane technology adsorption UV/Vis photocatalysis Biological treatment |
| Membrane | Removal Ability by Adsorption (3 h) * MO Peak Shift (pH Change) | Removal Ability by Photocatalysis (UVA-Blue Light, 3 h) | ||
|---|---|---|---|---|
| MB (C0 = 1.5 × 10−5 M) | MO (C0 = 2 × 10−5 M) | MB (C0 = 1.5 × 10−5 M) | MO (C0 = 2 × 10−5 M) | |
| Nafion | ≈70% | ≈35–40% * (pH = 6 to 3.7) | ≈82% | 47% |
| Nafion-TiO2 | ≈60% | ≈30% * (pH = 6 to 3.7) | ≈70% | 67% (TiO2 70mg/L, w/o Nafion: 72%) |
| Nafion-GO | 80% | ≈35% * (pH = 6à3.7) | ≈92% | 46% |
| Nexar | ≈94% | ≈20% (pH = 2) (no removal @pH = 6) | ≈90% | ≈29% |
| Nexar-TiO2 | ≈92% | ≈29% (pH = 2) | ≈90% | ≈71% (pH = 2) (≈20% @pH = 6) |
| Nexar-GO | ≈87% | ≈48% (pH = 2) (no removal @pH = 6) | ≈92% | ≈70% (pH = 2) (No removal @pH = 6) |
| Coating Layer | Qt of Fe3+ Ions (mg/g) | |
|---|---|---|
| 15 min | 180 min | |
| No coating (only PP) | 0.269 | 1.237 |
| s-PBC/PP | 1.019 | 3.124 |
| s-PBC-GO 0.17%/PP | 6.277 | 2.939 |
| s-PBC-GO 0.34%/PP | 6.096 | 3.261 |
| s-PBC-GO 0.67%/PP | 5.990 | 1.511 |
| Filter | Qt of Fe3+ Ions (mg/g) | Qt of Co2+ Ions (mg/g) | ||
|---|---|---|---|---|
| Adsorption (180 min) | Filtration | Adsorption (180 min) | Filtration | |
| PP | 0 | 0.30 | 0 | 5.46 |
| s-PBC@PP | 7.75 | 4.79 | 21 | 24 |
| s-PBCGO@PP | 5.86 | 5.10 | 37 | 21 |
Disclaimer/Publisher’s Note: The statements, opinions and data contained in all publications are solely those of the individual author(s) and contributor(s) and not of MDPI and/or the editor(s). MDPI and/or the editor(s) disclaim responsibility for any injury to people or property resulting from any ideas, methods, instructions or products referred to in the content. |
© 2024 by the authors. Licensee MDPI, Basel, Switzerland. This article is an open access article distributed under the terms and conditions of the Creative Commons Attribution (CC BY) license (https://creativecommons.org/licenses/by/4.0/).
Share and Cite
Filice, S.; Scuderi, V.; Scalese, S. Sulfonated Pentablock Copolymer (NexarTM) for Water Remediation and Other Applications. Polymers 2024, 16, 2009. https://doi.org/10.3390/polym16142009
Filice S, Scuderi V, Scalese S. Sulfonated Pentablock Copolymer (NexarTM) for Water Remediation and Other Applications. Polymers. 2024; 16(14):2009. https://doi.org/10.3390/polym16142009
Chicago/Turabian StyleFilice, Simona, Viviana Scuderi, and Silvia Scalese. 2024. "Sulfonated Pentablock Copolymer (NexarTM) for Water Remediation and Other Applications" Polymers 16, no. 14: 2009. https://doi.org/10.3390/polym16142009
APA StyleFilice, S., Scuderi, V., & Scalese, S. (2024). Sulfonated Pentablock Copolymer (NexarTM) for Water Remediation and Other Applications. Polymers, 16(14), 2009. https://doi.org/10.3390/polym16142009

